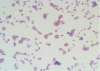

Diagnosis of Effusions Flashcards
What is an Effusion?
- Whether fluid accumulates or not- is just a clinical sign
- how much fluid is being produced or is coming in? How much is being drained?
- There is fluid constantly being made but it is always being drained normally

Reasons for Analysis


Fluid Analysis
- Need to collect in anticoagulant tube
- if it is inflammatory and has fibrinogen in it, will clot, and lead to false classification
- Need to identify types of cells and proportions

Normal Fluids (small animals)
- when it comes to the peritoneal spac, there is a very minute amount of fluid that just forms a smooth surface
- shouldnt really be able to draw up this fluid as it is just a protective film layer

Normal Fluid Appearance
- Hydrostatic presssure is what is pushing fluid out from capillaries
- oncotic pressure holds the fluid back
- difference between the two is generally a small pressure gradient
- IF YOU HAVE HEALTHY CAPILLARY WALL
- can have compromised wall for example that is too leaky
- or lymphatic drainage has been affected

Normal FLuid Regulation

Classification of Effusions
- Every time you classify a fluid
- modified is more of a lumping term
- Is based on total nuclear cell count and total protein

Transudate
- refers to passive movement of fluids across membranes
- gradient between two pressures will change and lead to transudation
- will have low cell count and total protein
- more watery

Transudate- cytology
- hunt for cells as they are far and few inbetween

Causes of Transudates
- generally look at albumin levels as it is the most abundant protein
- -if you have a SEVERE drop in albumin, then yes you will have enough of an oncotic pressure change to have transudation
- but people are born with less albumin and do not have this effect (ECHO)

Causes of Transudates
(hypoalbuminemia)
- If glomeruli are leaking, glomerularnephritis
- have fluid accumulations
- or if the liver is not producing albumin so there is not enough in circulation (overall loss in protein)
- These animals still only have a moderate decrease in oncotic pressure due to albumin deficiency though!

Hepatic Cirrhosis, Portal Hypertension, and Transudate formation
- This is more an issue on the hydrostatic pressure side
- blood will not be able to enter liver as well (portohypertension) and then there will be a discrepancy between pressures

stages after hepatic fibrosis
(diagram)
- if the congestion is behind the liver, when you have leakage of this protein, you see a low cell/protein fluid
- echo

Modified Transudate
- kind of lumps everything inbetween as a category
- still a relatively low cell count (moderate increase in TNCC and protein)
- bit more of a rich protein transudate
- more of a mixture of cells present as well - mixture of inflammatory cells

Modified transudate
dont need to look as hard for cells
Modified Transudate Histo
- If heart is failing, you will have a backup of pressure behind it
- that pressure is hydrostatic and therefore builds up
- depends on if oncotic pressure can keep up
- lymph drainage goes into vena cava, but if the low pressure system is affected, this drainage system will be an issue as well
- echo
- obstruction behind a tumor would lead to a similar drainage problem

Causes of Modified Transudate

Steps following Cardiac Failure
(diagram)
This type of congestion will affect the liver and will lead to the leakage of high protein lymph into the periotneal space
when the whole liver is congested, this is where we ooze out proteins

Exudate
- cells are actively recruited to come to the area
- the capillaries will be leakier and therefore the plasma is full of protein
- there is a lot of protein in the plasma
- macroscopically can actually look like pus: yellowish, turbent
- depends on how severe the inflammation is
- more common: neutrophils
- sometimes: eosinophils

Causes of Exudates
- Usually look for bacteria or any infectious causes
- long standing congestive process (heart failure), the fluid will start to affect surfaces over time and then lead to a possible exudate status due to resulting inflammation
- echo

Non-septic exudate and Septic Exudate
- FIP is a very inflammatory fluid, but is due to a VIRAL disease
- extracellular bacteria cant be taken often as it could be a (echo)


Septic Exudate - Cytology
can see that the bacteria has been phagocytosed
Septic Exudate
(degenerate neutrophils and bacteria)

FIP
(feline infectious peritonitis)
- often will have high protein concentration but the cell count can be relatively low or higher
- often: low cell count but high protein
- realistically the only thing that really works is doing immunoflorescence on the fluid for the virus, but will lable coronavirus as well?
- looking at fluid is not diagnostic enough to diagnose the fatal disease


FIP- Modified Transudate
lowish cellularity and high protein

Non-septic exudate cytology
these neutrophils look like the ones you would normally see in a blood smear - non degenerate?
Haemorrhage
- If you see this: immediately start thinking whether you hit a blood vessel, organ, or is it a hemorrhage??
- If you have blood looking fluid, do a PCV
a PCV of 2-3% will already look like this - you can get a better idea of how much blood is in there

Haemorrhage
(3 types)
- are there acrophages coming to eat the RBCs? (erythrophagia)
- echo
- platelets should disappear within seconds, if in peritoneal cavity they should adhere to surface in cavity!
- should not see platelets if true hemorrhage
- if you do: animal is actively bleeding or you hit a vessel
- if you are seeing macrophages with RBC’s, means it happened hours ago
- 2-3 days: will start to see siderophages and possibly haematoidin
- if you see both siderophages and RBC’s not broken down, then there is possible chronic bleeding
- when sending fluid to lab, make sure it is a fresh smear

Iatrogenic Haemorrhage- cytology


Acute Haemorrhage - cytology
can see RBC in the macrophage

Chronic Haemorrhage
macrophages with blue/black pink in them
hematoiden can be seen in them
Chylous effusion
- chylous effusion is the lymph that is coming from the intestines and if the animal is still eating or not severely anorexic
- will be milky due to the fat (that is the chylous effusion fluid you see)
- protein is variable and cell count is well depending on how long the process is going on
- lymph fluid is full of LYMPHOCYTES! (see this in acute)
- if this fluid keeps stnading in hte cavity, other cells will come in and dilute out your lymphocytes

Chylous effusion- cytology
- small lymphocytes
- acute

Chylous Effusion
(triglycerides)
- if you see a milky fluid (like milk and isnt pus) - full of fat!
- look for triglyceride value
- if high enough level, most likely for sure chylous effusion
- if the animal goes off food and you keep breaking down fat, the milkiness of that fluid can disappear

Mesothelial Cells and Neoplasia
- IF you can recognize the macrophages, neutrophils, lymphocytes (you can actually discover a lot in house)
- but avoid trying to note mesothelial cells as aggressive malignant cells as they get irritated normally in these situations
- reactive cells
- dont think they are carcinoma cells if they are just irritated mesothelial cells
- send off!


“normal” Mesothelial
reactive cells

Reactive mesothelial
will have different sizes of nuceli
will have a lot of same characteristics of cancerous cells!

Carcinoma
-need to have advanced diagnostic tests to identify these cells if in truth it is a carcinoma
Ectopic Sources of Fluid
- uroabdomen: leaking urine. almost looks like peritoneal fluid
- bile peritonitis: leakage of the bile
- pacreatitis: will have moderate amout of inflammation around pacreas

Biochemistry ratios - modified transudate/exudate
- If you are leaking urine into the abdomen recently: measure creatinine (slower to exit than urea) –> will indicate that this fluid is containing urine or is actally urine


Bile Pigment
macrophages are attacking bile pigment
Equine Peritoneal Fluid
- big difference between small animals and large animals
- with a massive animal, if there is expansion of the abdomen, there will be pooling at the bottom (ventral)
- it is rather common to tap into this fluid in a horse to have it analyzed (COLIC CASES)
- cannot do this in small animals
- very important to look at the fluid: is this a diagnostic tap or is there an actual accumulation of fluid (more fluid than normal)

Normal Equine Peritoneal Fluid
- normally the fluid can have a good amount of cells or protein - “moderate transudate”
- remember: is this a diagnostic tap or an abnormal accumulation of fluid?

Equine Peritoneal Fluid
(non- septic exudate)
- would be similar to SA
- if cell count goes high then it is self explanatory?
- echo

Equine Peritoneal Fluid
(septic exudate)
- look for bacteria
- horses has a unique protozoa in gut, so if there is leakage of the gut, can look for this abnormality in peritoneal cavity

Enterocentesis
- need to be gentle!
- -should be able to push away intestinal loops or intestine isnt as intact as it should be, you may get out fluid that is from the intestine
- will see bacteria and protozoa
- you shouldnt really see cells in this animal!
- is there perionitis, enterocentesis, acute rupture?–> factor in the whole clinical picture for this

Enterocentesis vs. Septic Inflammation

Summary
(4)
